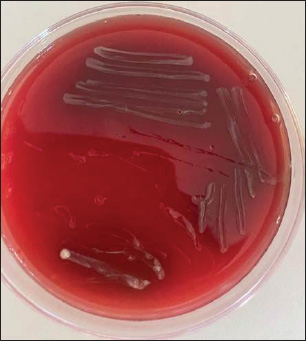

| Research Article | ||
Open Vet. J.. 2025; 15(7): 3148-3155 Open Veterinary Journal, (2025), Vol. 15(7): 3148-3155 Research Article Bacteriological and molecular characterization of B. melitensis isolated from aborted sheep and Malta fever patientsSaba Falah Klaif1, Luma Al-Bayati2,3, Hassan Al-Karagoly4,5* and Balsam Miri Mizher61Unite of Zoonotic Disease, College of Veterinary Medicine, University of Al-Qadisiyah, Al-Qadisiyah, Iraq 2Department of Microbiology, Faculty of Medicine, University of Wassit, Wassit, Iraq 3Medical Laboratories Techniques Department, College of Health and Medical Technologies / University of Kut, Wassit, Iraq 4Department of Internal and Preventive Medicine, College of Veterinary Medicine, University of Al-Qadisiyah, Al-Qadisiyah, Iraq 5College of Pharmacy, Alayen Iraqi University, Nasiriyah, Iraq 6Department of Microbiology, College of Veterinary Medicine, University of Al-Qadisiyah, Al-Qadisiyah, Iraq *Corresponding Author: Hassan Al-Karagoly. Department of Internal and Preventive Medicine, College of Veterinary Medicine, University of Al-Qadisiyah, Al-Qadisiyah, Iraq. Email: hassan.aliwee [at] qu.edu.iq; hassan.khalaf [at] alayen.edu.iq Submitted: 21/03/2025 Revised: 18/06/2025 Accepted: 23/06/2025 Published: 31/07/2025 © 2025 Open Veterinary Journal
ABSTRACTBackground: Zoonotic diseases are a major global health concern, particularly those with high prevalence or widespread impact. Brucella melitensis, the causative agent of human brucellosis or undulant fever, is a highly virulent pathogen that is transmitted mainly through contact with infected animals or consumption of unpasteurized dairy products. The significance lies in its public health impact and economic burden in endemic regions. Aim: This study aimed to isolate and identify B. melitensis from human patients and sheep using conventional and molecular techniques, with the goal of tracking its presence and genetic variations across both hosts. Methods: A total of 50 samples were collected from Al-Qadisiyah Province, Iraq, including 25 blood samples obtained via venipuncture from sheep owners clinically suspected of having Malta fever and 25 placenta samples aseptically collected from recently aborted ewes during field visits to local farms. We cultivated the collected samples on blood agar media and performed biochemical analysis using VITEK® 2 Compact 15 (V2C15). We also examined the samples using PCR and partial sequencing (PS) techniques, which used the 16S rRNA gene as the bacterial DNA target. Results: Classical bacteriological methods identified B. melitensis in 15 out of 25 (60%) human blood samples and 13 (52%) sheep placental samples. In V2C15, 13 (86.66%) and 11 (84%) human and sheep placental samples were positive for B. melitensis. PCR identified B. melitensis in 10 (76.9%) and 10 (90%) human and ewe placental samples, respectively. The partial gene sequencing (PGS) of two samples from humans and two samples from ewe placentas demonstrated isolates closely aligned with global isolates from China and India, respectively. Conclusion: The present study revealed continuous circulation of B. melitensis infection from sheep to humans in Al-Diwaniyah City, Iraq, and that the sequenced bacteria might have faced genetic evolution after they were descended from China or India isolates. Keywords: Brucella melitensis, Brucella phylogeny, Brucellosis, Abortion, Malta fever. IntroductionBrucellosis, a prevalent zoonotic disease on a worldwide basis, is attributed to bacteria belonging to the Brucella genus (Galinska and Zagórski, 2013). These bacteria, which are classified as Gram-negative proteobacteria, exhibit the characteristics of intracellular pathogenic organisms (Facciolà et al., 2018). Human brucellosis primarily relies on reservoirs and uses direct contact for transmission with infected animals or the ingestion of products contaminated with the pathogenic bacterium (Garofolo et al., 2017). Currently, Brucella melitensis, Brucella abortus, and Brucella suis continue to be the primary etiological agents (Kumar et al., 2011). Chronic infections resulting in severe complications in the human population pose a significant health challenge (Charypkhan et al., 2019). The epidemiological status of brucellosis continues to be complicated, with significant outbreaks occurring in numerous low-income nations, such as countries encompassing the area around the Mediterranean Sea, South America, Africa, Middle East (Pappas et al., 2006). Brucellosis is a major community health concern in rural and agricultural regions, despite its relatively low mortality rates (O’Brien et al., 2017). Brucellosis remains a significant public health and economic concern in Iraq. Epidemiological studies have reported substantial morbidity in livestock, with obvious prevalence rates of 6.51% in sheep and goats, 1% in cattle, and 1.48% in buffalo (Alshwany, 2019). Human brucellosis incidence exceeded 27.2 cases per 100,000 population in 2002, though it declined to less than 4 cases per 100,000 following expanded vaccination campaigns (Garfield and Waldman, 2003). Economically, brucellosis imposes severe burdens—an analysis in the Dohuk governorate estimated annual losses of approximately US$1.52 million due to reduced milk production and pregnancy losses (Alshwany, 2019). Immunization efforts, particularly the use of Rev. 1 vaccine in small ruminants, have proven effective. Over a projected 20-year period, these campaigns are expected to reduce seroprevalence from 9.22% to 0.73%, with a favorable benefit–cost ratio of 4.25 and a net present value of US$10.56 million (Blasco, 1997; Al-Hamada, 2021). These data underscore the need for continued surveillance and control strategies, thereby justifying the relevance and necessity of this study. Brucellosis significantly affects the global economy and community health negatively. Every year, there are between 5 and 12.5 million cases of brucellosis in people, indicating that it is a widespread zoonotic disease worldwide (Głowacka et al., 2018). Brucellosis causes serious illness and may result in mortality due to complications (Hull and Schumaker, 2018; Bagheri Nejad et al., 2020). Prolonged disease duration can persist for multiple years. Successful treatment requires the patient to adhere to rigorous, costly, and prolonged treatment protocols. Brucellosis also has a significant negative impact on animal health and production. It induces abortion during the later stages of pregnancy, leads to congenital abnormalities or fetal death during birth, and can result in retention of the placenta and reduction in milk production of up to 30% (Hull and Schumaker, 2018). The biggest dangers of brucellosis in humans involve contact with diseased animals or consumption of their uncooked products. Nonetheless, additional risk factors may influence animal exposure or consumption of raw products, which could indirectly intensify the problem (Havas et al., 2013). Demographic characteristics, such as work, can influence the frequency of interaction with sick animals. Regional cultures and traditional beliefs can also influence people’s attitudes toward raw dairy products. It is critical to note that the aforementioned risk factors vary among areas within countries as well as between countries, contributing to the disparities in brucellosis prevalence rates across geographical locales (Al-Shamahy et al., 2000; Holt et al., 2011). Epidemiological tracking is critical for identifying sources with a high chance of harboring causal agents. Researchers frequently use molecular-based tracking, such as PCR, due to the strong and specific relationship between infectious agents and possible sources (Georgi et al., 2017; Sayour et al., 2020). Animal-originating infectious diseases receive ongoing critical attention, especially when they are endemic or of global concern (Bardenstein et al., 2023). The main purpose of the current study was to investigate the zoonotic link and epidemiological distribution of Brucella melitensis in humans and sheep, while its specific objectives included isolating, identifying, and tracking the pathogen using both conventional and molecular methods. Materials and MethodsSamplesFifty samples (25 blood samples from sheep owners suspected of having Malta fever, and 25 placentas from aborted ewes) were collected to isolate and identify B. melitensis. The samples were collected from Al-Diwaniyah City, located in the southern central region of Iraq, during the period from July to October 2024. The bacterial samples were handled in accordance with the biosafety guidelines of the microbiology laboratory. The blood samples were cultured on blood agar according to the previous research (Alton et al., 1988; Corbel, 1988; Lopez et al., 2006). Aseptic techniques were used to process the tissue samples and eliminate potential contaminants. The specimens were then mechanically disrupted and homogenized using a tissue grinder in the presence of a small volume of sterile phosphate-buffered saline (PBS). The resulting homogenates were inoculated onto blood agar plates and incubated at 37 °C under two atmospheric conditions: ambient air and an environment supplemented with 5%–10% CO2. Cultures were first inspected on day 4 after inoculation and then observed daily for two weeks to detect Brucella spp. Identification was based on colony morphology and was confirmed using the V2C15 system. DNA extractionDNA extraction was performed using the NOVOGEN® Genomic DNA Kit (France), following the supplier’s instructions. The quantity and quality of DNA were evaluated using a NanoDrop spectrophotometer, and samples were kept at −20 °C for future analyses. Polymerase chain reaction (PCR)Primers targeting the Brucella melitensis 16S rRNA gene were designed specifically for this study. The forward primer sequence was 5′-CAAGGGCTGGTAAGGTTCTG-3′ and the reverse primer sequence was 5′-AGCCACACTGGGACTGAGAC-3′. The primer design was performed using the NCBI Primer-BLAST tool, ensuring specificity and compatibility with standard PCR conditions. PCR amplification was performed using a commercially available master mix, following the protocol recommended by the manufacturer. The cycling conditions were as follows: initial denaturation at 94 °C for 30 seconds; 35 cycles of denaturation at 94 °C for 30 seconds, annealing at 53 °C for 30 seconds, and extension at 72 °C for 60 seconds; followed by a final extension at 72 °C for 7 minutes. Amplification of the target 650-bp fragment of the 16S rRNA gene was confirmed by electrophoresis on a 0.8% agarose gel stained with ethidium bromide. Visualization was performed using a UV transilluminator. Partial 16S rRNA gene sequencingThe current study focused on sequencing the 16S rRNA gene in four separate isolates of B. melitensis, namely two isolates from humans and two isolates from sheep. The PCR agarose gel results were extracted using an EZ-10 Spin Column DNA Gel Extraction Kit (Biobase, Canada). The products were sent to the Bioneer Company in Korea for the purpose of carrying out the gene. The entire sequences were deposited into the GenBank-NCBI database, where a web-based tool was employed to perform the alignment. Subsequently, the BLAST (NCBI) database was employed to assess the matched sequences based on the degree of shared homology, with the aim of categorizing the bacterium. The phylogenetic tree was computed by recruiting the neighbor-joining method using MEGA (X) software. Ethical approvalThe current study was conducted after collecting patient consent, and all international criteria for animal care and use were followed. Ethical approval for this study was obtained from the Research Ethics Committee of the College of Veterinary Medicine, University of Al-Qadisiyah, under Approval No. 3925, dated October 2024. ResultsColony morphology and conventional identificationOn Brucella agar, B. melitensis forms small, circular colonies typically measuring 1–2 mm in diameter after 48 to 72 hours of incubation. The colonies appear smooth, convex, and moist, with an entire margin and a glistening surface. The color ranges from translucent to opaque, often with a creamy or grayish-white appearance. The consistency may be buttery or slightly mucoid depending on the strain (Fig. 1). These phenotypic characteristics were consistent across both human and ewe placental samples. Biochemical confirmation using conventional methods identified B. melitensis in 15 (60%) of 25 human samples and 13 (52%) of 25 ewe samples. Under the microscope, B. melitensis appeared as small, Gram-negative coccobacilli. These bacteria typically measured about 0.5–0.7 µm in width and 0.6–1.5 µm in length. They were usually observed as single cells but also occurred in pairs or short chains. B. melitensis was nonmotile, nonspore-forming, and lacked a capsule. It did not retain acid-fast stains and often showed faint or uneven staining due to its intracellular nature (Fig. 2). V2C15 identificationA total of 15 human and 13 ewe placental samples were tested using the V2C15 system. Among these, 13 human samples (86.66%) and 11 ewe samples (84%) tested positive for B. melitensis. The V2C15 results corroborated the findings of the conventional methods, providing faster and automated confirmation of the bacterial identity (Table 1).
Fig. 1. Small, circular colonies (1–2 mm), appearing smooth, moist, convex, with entire margins and a glistening, creamy, to grayish-white surface.
Fig. 2. Small, Gram-negative coccobacilli are seen singly, in pairs, or short chains, nonmotile, nonspore-forming, lack a capsule, and show faint staining due to their intracellular nature. PCR detection of 16S rRNA genePCR assays targeting the 16S rRNA gene of B. melitensis revealed amplification in 10 (76.9%) of 13 V2C15-positive human samples and 10 (90%) of 11 ewe samples (Fig. 3). The PCR products showed clear bands of the expected size when analyzed using agarose gel electrophoresis (Fig. 4), further validating the accuracy of earlier identification methods. Table 1. Prevalence of B. melitensis according to different identification methods.
Fig. 3. Map of Iraq and Al-Diwaniyah Province showing the spatial distribution of positive and negative B. melitensis cases in both humans and animals. Partial sequencing and phylogenetic analysisPartial sequencing of the 16S rRNA gene was performed on two representative positive samples from each host group. Sequence alignment and phylogenetic analysis indicated a high degree of similarity with B. melitensis strains isolated from China (human samples) and India (ewe samples). The phylogenetic relationships are illustrated in Figure 4 and Figure 5, showing the clustering of local isolates with reference strains from GenBank. DiscussionIn Iraq, brucellosis is classified as a notifiable disease in both humans and animals, meaning that any confirmed cases must be reported to public health and veterinary authorities (Salih, 2010). Mandatory disease reporting remains a cornerstone of epidemiological surveillance, enabling rapid outbreak identification, optimal resource allocation, and precise intervention strategies (Taboy et al., 2010). Improving the consistency and robustness of reporting systems can enhance prevalence estimates and support public health planning. Professionals in the human and animal care sectors must remain informed of these requirements to ensure prompt data reporting (Aturinde, 2020). This study provides analytical perspectives on the role of B. melitensis as an important cause of reproductive illnesses in sheep in Al-Diwaniyah City. The classical microbiological approach was used to confirm infection in ovine and human placental tissues. Furthermore, V2C15-based identification, PCR, and 16S rRNA gene sequencing were applied to confirm the results of routine methods. Notably, this is the first attempt in the region to apply both traditional and molecular methods simultaneously for human and animal cases, thus contributing valuable data to brucellosis control programs. Previous serological studies in Iraq, while useful, have limitations in terms of specificity and scope. In this context, (Alhamada et al., 2017) used the Rose Bengal and ELISA tests and reported a 31.7% sheep seroprevalence, but the study’s diagnostic limitations restricted its generalizability. In contrast, our integration of PCR and sequencing yielded higher diagnostic accuracy and allowed for initial phylogenetic profiling. This study identified a notable variation in the prevalence of B. melitensis compared with samples collected from Duhok Province, northern Iraq. These findings are consistent with those reported by Ilyas and Karakuş (2019), who documented elevated prevalence rates of B. melitensis in animals from specific districts within the same region. The current study’s findings align with similar reports from diverse regions, reflecting the broad geographic presence of B. melitensis in small ruminants. In this context, this pathogen has been found in different animal samples, including aborted fetuses, vaginal secretions, and uterine tissues, in various regions of the world, including Jordan (Samadi et al., 2010), Mexico (Herrera et al., 2011), and Malaysia (Bamaiyi et al., 2012). It has also been isolated from the dairy products of sheep and goats in Iran (Shakerian et al., 2016), supporting the widespread distribution and public health importance as a zoonotic pathogen. PCR detection levels in this study correspond well with prior research, such as the work by (Cvetnić et al., 2015), who isolated B. melitensis from 14 of 336 samples from cattle, goats, and sheep. Similarly, (Sumathi et al., 2019) identified five isolates from infected sheep farms by PCR targeting species-specific genes. Moreover, (Tekle et al., 2023) identified eight genetically diverse B. melitensis strains lacking the usual 1682 bp amplicon, although molecular and phenotypic confirmation verified their identity, emphasizing the genetic diversity within the species. Genetic sequencing of human and ovine placenta isolates revealed strong similarity with strains previously documented in China and India. This pattern indicates the possible cross-border transmission of B. melitensis, which is potentially driven by the trade and movement of livestock. Such findings are consistent with those of Zhu et al. (2020), who highlighted the organism’s genomic adaptability and international spread.
Fig. 4. Agarose gel electrophoresis of B. melitensis isolated from sheep owners and aborted ewe placentas. M: ladder; 1 and 2: Human blood samples; 3 and 4: ewe placentas.
Fig. 5. Phylogenetic tree of B. melitensis isolated from sheep owners and aborted ewe placentas. These results reinforce the urgent need for a One Health approach to combat brucellosis—a zoonotic disease with serious implications for human and animal health. A unified response involving public health officials, veterinarians, and environmental specialists is key to strengthening surveillance, diagnostics, and preventive measures. Despite its proven value, One Health remains under-applied, particularly in endemic areas. Increasing professional awareness and fostering cross-sector collaboration are essential to enhance brucellosis control, in line with recent calls for comprehensive One Health strategies in managing zoonotic threats (Meurer et al., 2024). Study limitationsThis study presents several constraints that should be considered. First, its focus on Al-Diwaniyah City limits the applicability of the findings to other regions with potentially different disease dynamics. Second, due to biosafety and practical limitations, culture-based methods—considered the diagnostic benchmark—could not be applied to all specimens, possibly influencing the accuracy of pathogen identification. Third, the cross-sectional nature of the study prevented evaluation of disease progression over time or identification of seasonal fluctuations. Additionally, although molecular diagnostics were effective, the lack of comparative analysis with a wider range of international reference sequences reduced the depth of the phylogenetic interpretation. Finally, limitations in infrastructure and available resources have hindered the extent of laboratory testing and the overall scope of epidemiological monitoring. ConclusionThe combined use of traditional microbiological methods, automated identification systems, and molecular tools enabled a comprehensive evaluation of Brucella melitensis infections among humans and livestock in Al-Diwaniyah, Iraq. The considerable infection rate underscores the public health relevance of this zoonosis and highlights the urgent need for better diagnostic infrastructure, regular monitoring, and unified control strategies. Adopting a One Health approach—encompassing livestock immunization, targeted awareness campaigns, and strengthened collaboration across the human and veterinary sectors—is critical for reducing the impact of brucellosis in Iraq and similar endemic areas. AcknowledgmentsThe author extends his appreciation to College of Veterinary Medicine, University of Al-Qadisiyah, Iraq, and to the Faculty of Medicine, University of Wassit, Wassit, Iraq, for their technical support. FundingThe authors confirm that this manuscript received no external funding. Author contributionsThe conceptualization, methodology, and formal analysis were carried out by Balsam Miri Mizher, Saba Falah Klaif, and Luma Al-Bayati. Hassan Al-Karagoly and Saba Falah Klaif were responsible for the investigation, data curation, and study validation. Visualization and initial draft preparation were done by Hassan Al-Karagoly and Luma Al-Bayati. The writing, review, and editing process were conducted by Hassan Al-Karagoly and Balsam Miri Mizher. Supervisory duties were undertaken by Hassan Al-Karagoly, and project administration was managed by Hassan Al-Karagoly and Luma Al-Bayati. Publication fees will be paid by Hassan Al-Karagoly. All authors approved the final version of the manuscript. Conflict of interestThere are no conflicts of interest to declare regarding this work. Data availability statementThe data supporting the findings of this study are not publicly available owing to privacy considerations but may be obtained from the corresponding author upon reasonable request. ReferencesAl-Hamada, A. 2021. An epidemiological study of the impact of Toxoplasma gondii and Brucella melitensis on reproduction in sheep and goats in Dohuk Province, Iraq. Murdoch University, Murdoch, Australia. Alhamada, A.G., Habib, I., Barnes, A. and Robertson, I. 2017. Risk factors associated with Brucella seropositivity in sheep and goats in Duhok Province, Iraq. Vet. Sci. 4, 65. Al-Shamahy, H., Whitty, C. and Wright, S. 2000. Risk factors for human brucellosis in Yemen: a case control study. Epidemiol. Infect. 125, 309–313. Alshwany, E.A.A. 2019. The epidemiology of brucellosis in sheep, goats and humans in the Iraqi Kurdistan Region. Murdoch, Australia: Murdoch University. Alton, G.G., Jones, L.M., Angus, R. and Verger, J. 1988. Techniques for the brucellosis laboratory. Institut National de la Recherche Agronomique (INRA). Aturinde, A. 2020. GIS and health: enhancing disease surveillance and intervention through spatial epidemiology. Lund: Lund University. Bagheri Nejad, R., Krecek, R.C., Khalaf, O.H., Hailat, N. and Arenas-Gamboa, A.M. 2020. Brucellosis in the Middle East: Current situation and a pathway forward. PLoS Negl. Trop. Dis. 14, e0008071. Bamaiyi, P.H., Hassan, L., Khairani-Bejo, S., Zainal Abidin, M., Ramlan, M., Krishnan, N., Adzhar, A., Abdullah, N., Hamidah, N. and Norsuhanna, M. 2012. Isolation and molecular characterization of Brucella melitensis from seropositive goats in Peninsula Malaysia. BMC Vet. Res. 29(4), 513–8. Bardenstein, S., Grupel, D., Blum, S.E., Motro, Y. and Moran-Gilad, J. 2023. Public and animal health risks associated with spillover of Brucella melitensis into dairy farms. Microb. Genom. 9, 001014. Blasco, J.M. 1997. A review of the use of Brucella melitensis Rev 1 vaccine in adult sheep and goats. Prev. Vet. Med. 31, 275–283. Charypkhan, D., Sultanov, A.A., Ivanov, N.P., Baramova, S.A., Taitubayev, M.K. and Torgerson, P.R. 2019. Economic and health burden of brucellosis in Kazakhstan. Zoonoses Public Health 66, 487–494. Corbel, M.J. 1988. International committee on systematic bacteriology subcommittee on the taxonomy of Brucella: report of the Meeting, 5 September 1986, Manchester, England. Int. J. Syst. Evol. Microbiol. 38, 450–452. Cvetnić, Ž., Zdelar-Tuk, M., Duvnjak, S., Račić, I., Škrivanko, M. and Špičić, S. 2015. Multiple locus variable number of tandem repeat analysis (MLVA) of isolates of Brucella melitensis isolated in the Republic of Croatia. Vet. Arhiv 85, 481–492. Facciolà, A., Palamara, M.A., D’Andrea, G., Marano, F., Magliarditi, D., Puglisi, G., Picerno, I., Di Pietro, A. and Visalli, G. 2018. Brucellosis is a public health problem in southern Italy: Burden and epidemiological trend of human and animal disease. J. Infect. Public Health 11, 861–866. Galinska, E.M. and Zagórski, J. 2013. Brucellosis in humans—etiology, diagnostics, clinical forms. Ann. Agric. Environ. Med. 20, 233–8. Garfield, R. and Waldman, R. 2003. Review of potential interventions to reduce child mortality in Iraq. UNICEF Technical Paper. Garofolo, G., Di Giannatale, E., Platone, I., Zilli, K., Sacchini, L., Abass, A., Ancora, M., Cammà, C., Di Donato, G. and De Massis, F. 2017. Origins and global context of Brucella abortus in Italy. BMC Microbiol. 17, 1–7. Georgi, E., Walter, M.C., Pfalzgraf, M.-T., Northoff, B.H., Holdt, L.M., Scholz, H.C., Zoeller, L., Zange, S. and Antwerpen, M.H. 2017. Whole genome sequencing of Brucella melitensis isolated from 57 patients in Germany reveals high diversity in strains from Middle East. PLoS One 12, e0175425. Głowacka, P., Żakowska, D., Naylor, K., Niemcewicz, M. and Bielawska-Drozd, A. 2018. Virulence factors, pathogenesis and treatment. Pol. J. Microbiol. 67, 151–161. Havas, K., Ramishvili, M., Navdarashvili, A., Hill, A., Tsanava, S., Imnadze, P. and Salman, M. 2013. Risk factors associated with human brucellosis in the country of Georgia: a case-control study. Epidemiol. Infect. 141, 45–53. Herrera, E., Rivera, A., Palomares, E.G., Hernández-Castro, R. and Díaz-Aparicio, E. 2011. Isolation of Brucella melitensis from a RB51-vaccinated seronegative goat. Trop. Anim. Health Prod. 43, 1069–1070. Holt, H.R., Eltholth, M.M., Hegazy, Y.M., El-Tras, W.F., Tayel, A.A. and Guitian, J. 2011. Brucella spp. infection in large ruminants in an endemic area of Egypt: cross-sectional study investigating seroprevalence, risk factors and livestock owner’s knowledge, attitudes and practices (KAPs). BMC Public Health 11, 1–10. Hull, N.C. and Schumaker, B.A. 2018. Comparisons of brucellosis between human and veterinary medicine. Infect. Ecol. Epidemiol. 8, 1500846. Ilyas, N.M. and Karakuş, F. 2019. Seroprevalence of brucellosis in sheep and goats in Duhok and Sumel districts of northern Iraq. Int. J. Sci. Technol. Res. 5, 37–41. Kumar, S., Tuteja, U., Sarika, K., Singh, D.K., Kumar, A. and Kumar, O. 2011. Rapid multiplex PCR assay for the simultaneous detection of the Brucella genus, B. abortus, B. melitensis, and B. suis. J. Microbiol. Biotechnol. 21, 89–92. Lopez, G., Escobar, G., Ayala, S. and Lucero, N. 2006. Detection of antibodies to Brucella ovis in sheep milk using B. ovis and B. canis antigen. Vet. Microbiol. 116, 232–238. Meurer, I.R., Silva, M.R., Roland, R.K., Corrêa, J.O.A. and Coimbra, E.S. 2024. Evaluation of medical professionals’ knowledge about Q fever. Sci. Med. 34, e45474. O’Brien, M.P., Beja-Pereira, A., Anderson, N., Ceballos, R.M., Edwards, W.H., Harris, B., Wallen, R.L., Costa, V. and Luikart, G. 2017. Brucellosis transmission between wildlife and livestock in the Greater Yellowstone Ecosystem: Inferences from DNA genotyping. J. Wildl. Dis. 53, 339–343. Pappas, G., Papadimitriou, P., Akritidis, N., Christou, L. and Tsianos, E.V. 2006. The new global map of human brucellosis. Lancet Infect. Dis. 6, 91–99. Salih, H.M.S. 2010. Brucellosis in Iraq: Epidemiology, present status, and challenges in controlling the disease. Kansas: Kansas State University. Samadi, A., Ababneh, M.M., Giadinis, N. and Lafi, S. 2010. Ovine and caprine brucellosis (Brucella melitensis) in aborted animals in Jordanian sheep and goat flocks. Vet. Med. Int. 2010, 458695. Sayour, A.E., Elbauomy, E., Abdel-Hamid, N.H., Mahrous, A., Carychao, D., Cooley, M.B. and Elhadidy, M. 2020. MLVA fingerprinting of Brucella melitensis circulating among livestock and cases of sporadic human illness in Egypt. Transbound. Emerg. Dis. 67, 2435–2445. Shakerian, A., Deo, P., Rahimi, E., Shahjavan, A.-R. and Khamesipour, F. 2016. Molecular detection of Brucella melitensis in sheep and goat milk in Iran. Trop. J. Pharm. Res. 15, 913–918. Sumathi, B., Veeregowda, B., Byregowda, S., Rathnamma, D., Isloor, S., Shome, R. and Narayanaswamy, H. 2019. Molecular characterization of Brucella melitensis field isolates by Bruce-ladder multiplex PCR. Int. J. Curr. Microbiol. App. Sci. 8, 2019. Taboy, C.H., Chapman, W., Albetkova, A., Kennedy, S. and Rayfield, M.A. 2010. Integrated disease investigations and surveillance planning: a systems approach to strengthening national surveillance and detection of events of public health importance in support of the International Health Regulations. BMC Public Health 10, 1–6. Tekle, M., Legesse, M. and Mamo, G. 2023. Seropositivity, comparison between the efficiency of serological tests and risk factors of Brucella infection in small ruminants with history of abortion in the Afar Region of North-Eastern Ethiopia. Vet. Med. Res. Rep. 2023, 245–252. | ||
| How to Cite this Article |
| Pubmed Style Klaif SF, Al-bayati L, Al-karagoly H, Mizher BM. Bacteriological and molecular characterization of B. melitensis isolated from aborted sheep and Malta fever patients. Open Vet. J.. 2025; 15(7): 3148-3155. doi:10.5455/OVJ.2025.v15.i7.26 Web Style Klaif SF, Al-bayati L, Al-karagoly H, Mizher BM. Bacteriological and molecular characterization of B. melitensis isolated from aborted sheep and Malta fever patients. https://www.openveterinaryjournal.com/?mno=248669 [Access: January 26, 2026]. doi:10.5455/OVJ.2025.v15.i7.26 AMA (American Medical Association) Style Klaif SF, Al-bayati L, Al-karagoly H, Mizher BM. Bacteriological and molecular characterization of B. melitensis isolated from aborted sheep and Malta fever patients. Open Vet. J.. 2025; 15(7): 3148-3155. doi:10.5455/OVJ.2025.v15.i7.26 Vancouver/ICMJE Style Klaif SF, Al-bayati L, Al-karagoly H, Mizher BM. Bacteriological and molecular characterization of B. melitensis isolated from aborted sheep and Malta fever patients. Open Vet. J.. (2025), [cited January 26, 2026]; 15(7): 3148-3155. doi:10.5455/OVJ.2025.v15.i7.26 Harvard Style Klaif, S. F., Al-bayati, . L., Al-karagoly, . H. & Mizher, . B. M. (2025) Bacteriological and molecular characterization of B. melitensis isolated from aborted sheep and Malta fever patients. Open Vet. J., 15 (7), 3148-3155. doi:10.5455/OVJ.2025.v15.i7.26 Turabian Style Klaif, Saba Falah, Luma Al-bayati, Hassan Al-karagoly, and Balsam Miri Mizher. 2025. Bacteriological and molecular characterization of B. melitensis isolated from aborted sheep and Malta fever patients. Open Veterinary Journal, 15 (7), 3148-3155. doi:10.5455/OVJ.2025.v15.i7.26 Chicago Style Klaif, Saba Falah, Luma Al-bayati, Hassan Al-karagoly, and Balsam Miri Mizher. "Bacteriological and molecular characterization of B. melitensis isolated from aborted sheep and Malta fever patients." Open Veterinary Journal 15 (2025), 3148-3155. doi:10.5455/OVJ.2025.v15.i7.26 MLA (The Modern Language Association) Style Klaif, Saba Falah, Luma Al-bayati, Hassan Al-karagoly, and Balsam Miri Mizher. "Bacteriological and molecular characterization of B. melitensis isolated from aborted sheep and Malta fever patients." Open Veterinary Journal 15.7 (2025), 3148-3155. Print. doi:10.5455/OVJ.2025.v15.i7.26 APA (American Psychological Association) Style Klaif, S. F., Al-bayati, . L., Al-karagoly, . H. & Mizher, . B. M. (2025) Bacteriological and molecular characterization of B. melitensis isolated from aborted sheep and Malta fever patients. Open Veterinary Journal, 15 (7), 3148-3155. doi:10.5455/OVJ.2025.v15.i7.26 |